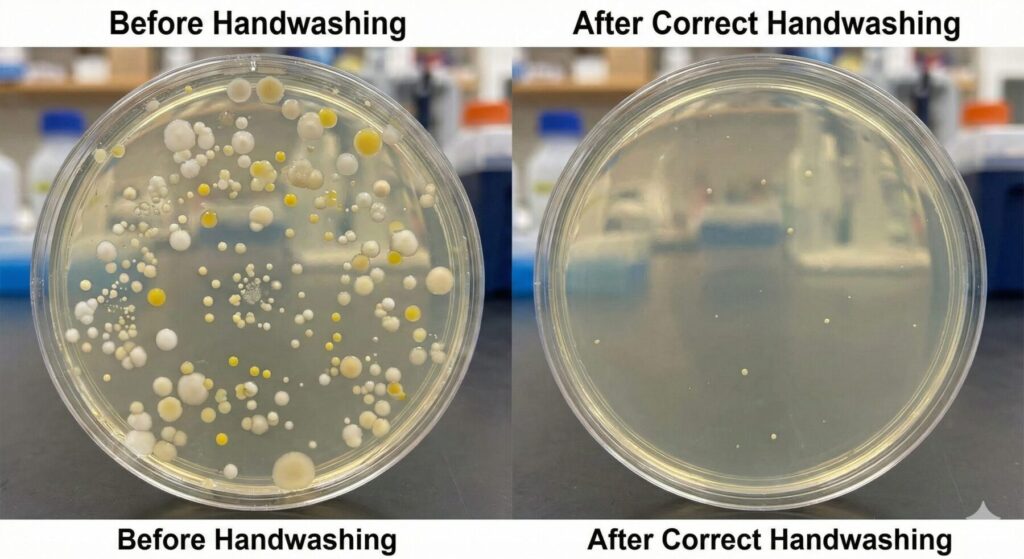

飲食店や食品工場の現場で、耳にタコができるほど言われる言葉。 それが**「手洗い」**ですよね。
「手を洗うなんて、子供でも知ってるよ」 そう思うかもしれませんが、私が15年間見てきた現場の中で、「プロとして正しい手洗い」ができている人は、実は驚くほど少ないのが現実です。
今回は、スタッフさんが「えっ、今までの手洗いじゃダメだったの?」とハッとして、納得して動いてくれるようになる「手洗いのプロ技」をお伝えします。
1. 【衝撃の事実】手洗い前と後、菌の数はこんなに違う!
私が飲食料品製造メーカーにいた頃、新人研修で必ず見せていたものがあります。 それは、**「手洗い前」と「手洗い後」の手のひらをスタンプした寒天培地(菌を培養するお皿)**の写真です。
百聞は一見にしかず。その差は歴然です。
- 手洗い前(Before): お皿一面に、白や黄色の菌のコロニー(塊)がびっしり……。「こんな手で食材を触っていたの?」と誰もが青ざめます。
- 正しい手洗い後(After): 菌がゼロになるわけではありませんが、コロニーの数は劇的に減り、ポツポツと見える程度になります。
なぜ「2度洗い」が推奨されるのか?
「1回洗えば十分でしょ?」と思うかもしれませんが、食品を扱うプロの現場では**「2度洗い」**が基本です。
なぜなら、1度目の手洗いでは、手のしわや爪の間に入り込んだ汚れや菌を完全に落としきれないことが多いからです。 一般的なデータでは、1度洗いでは数%〜十数%の菌が残ると言われていますが、2度洗いをすることで、その残った菌をさらに劇的に減らすことができます。
面倒でも「石鹸で洗って流す」を2回繰り返す。これがプロの鉄則です。
2. アルコール消毒を「無意味」にしてしまうNG行動
手洗いの仕上げに欠かせないアルコール消毒。 ですが、現場では**「せっかくのアルコール効果を台無しにしている」**残念な光景をよく見かけます。
知っておくべきアルコールの真実がこちらです。
真実①:手が濡れていたら効果は「ほぼゼロ」
これが最も多いNGです! アルコール消毒液は、最も殺菌効果が高い**「適切な濃度(一般的に70〜80%前後)」**に調整されています。
もし、手が水で濡れたままアルコールをかけたらどうなるでしょうか? 水で薄まって濃度が下がり、**ただの「アルコール風味の水」**になってしまいます。これでは菌は死にません。
「ペーパータオルで水分を完全に拭き取ってから、アルコール」 これが鉄則です。
真実②:アルコールに「持続性」はない!
ここも勘違いしやすいポイントです。 アルコール消毒は、かけた瞬間にそこにいる菌を殺す効果はありますが、その後の効果は続きません。
揮発して(乾いて)しまえば、消毒効果はなくなります。手に「抗菌バリア」を作るわけではないので、消毒した後に汚れたものを触れば、手はまたすぐに汚染されてしまいます。
「さっき消毒したから大丈夫」は通用しません。汚れたら、また洗う。この繰り返しが重要です。
3. 「やり方」より「タイミング」を教えよう
忙しいランチタイム。スタッフに「毎回30秒かけて2度洗いしろ」と言っても、現実的には難しい瞬間がありますよね。
私がカフェの現場で伝えているのは、完璧な手順よりも**「絶対に洗わなければいけないタイミング(急所)」**を外さないことです。
【絶対に洗うべき「汚染」のタイミング】
- 納品(段ボール)を触った直後
- **レジ(お金)**を触った後
- トイレから戻った時
- 髪の毛や顔を触った時
- 清掃用具(ダスターなど)を触った、ゴミを拾った後
特に**「そのままお客様の口に入るもの(サラダ、サンドイッチ、盛り付けなど)」を触る直前**は、何がなんでも手を洗う。この意識付けが食中毒を防ぎます。
まとめ:手洗いは「お客様への思いやり」
手洗いは、自分を守るためでもありますが、何より「大切なお客様に安全な食事を楽しんでもらうため」の行動です。
店長さんやリーダーの方は、ぜひ一度、スタッフさんの前で**「正しい手洗い(2度洗い+水分を拭き取ってからのアルコール)」を実演**して見せてあげてください。 「一緒にやる」姿勢が、一番の教育になりますよ!
次回のテーマは:「冷蔵庫を過信しないで!食材の命を守る『正しい詰め方』と温度記録のコツ」をお届けします。
